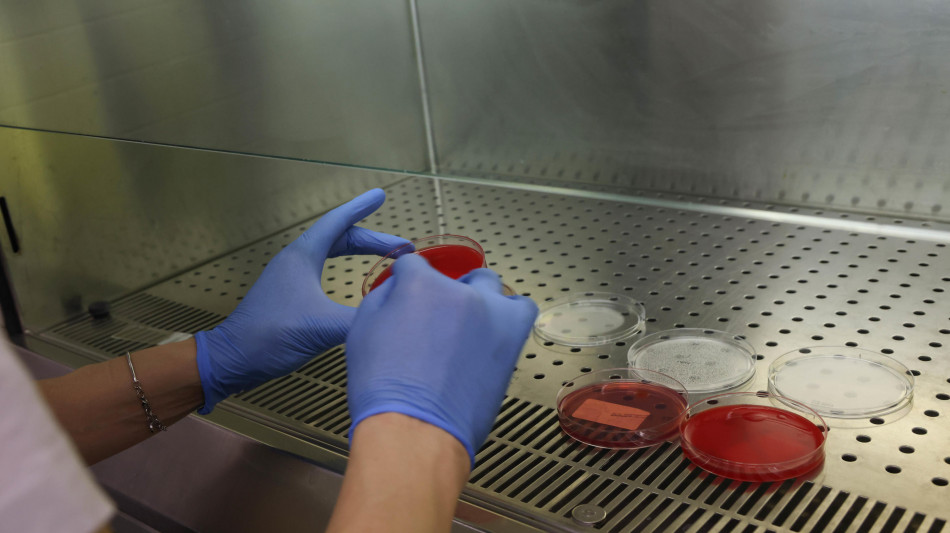
Malattie del sangue, ok Aifa rimborsabilità farmaco per Epn

Malattie del sangue, ok Aifa rimborsabilità farmaco per Epn
Terapia orale iptacopan per emoglobinuria parossistica notturna
È stata approvata dall'Aifa la rimborsabilità di iptacopan, il primo farmaco monoterapico orale sviluppato da Novartis per il trattamento dell'emoglobinuria parossistica notturna (Epn) nei pazienti adulti che rimangono anemici dopo almeno tre mesi di terapia con un inibitore di C5. L'Epn è una patologia rara e cronica del sangue causata da una mutazione acquisita nelle cellule staminali ematopoietiche, che porta alla produzione di globuli rossi privi di proteine protettive, rendendoli vulnerabili alla distruzione prematura da parte dal sistema del complemento (una parte del sistema immunitario), causando emolisi. Si stima che questa patologia colpisca circa mille persone in Italia - con diagnosi in giovane età, tra i 30 e i 40 anni - e di queste circa un terzo necessita di una terapia dell'anti-complemento. L'emolisi costante può causare trombosi, anemia, fatigue (affaticamento cronico) e altri sintomi. La fatigue è uno dei sintomi più debilitanti della malattia: oltre il 75% dei pazienti già in trattamento continua a convivere con una stanchezza costante, con difficoltà nelle attività fisiche di base. "Con questa nuova opzione terapeutica, quale il primo inibitore del fattore B, possiamo porci obiettivi terapeutici più ambiziosi: la normalizzazione del livello di emoglobina, il controllo completo dei sintomi e il miglioramento complessivo della qualità della vita - spiega Camilla Frieri, Uoc ematologia e terapie cellulari avanzate, dell'azienda ospedaliera San Giuseppe Moscati di Avellino. - Inoltre, la somministrazione orale rappresenta un'importante evoluzione, liberando i pazienti dalla routine ospedaliera e alleggerendo il carico fisico, emotivo e organizzativo delle infusioni"
(V.Blanchet--LPdF)


